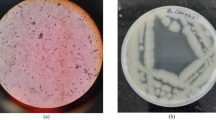

Abstract
Microbiologically induced calcite precipitation in bricks by bacterium Bacillus pasteurii (NCIM 2477) using a media especially optimized for urease production (OptU) was demonstrated in this study. Effect of biocalcification activity on compressive strength and water absorption capacity of bricks was investigated. Various other parameters such as pH, growth profile, urease activity, urea breakdown and calcite precipitated were monitored during the 28 days curing period. Efficiency of B. pasteurii to form microbial aided calcite precipitate in OptU media resulted into 83.9 % increase in strength of the bricks as compared to only 24.9 % with standard media, nutrient broth (NB). In addition to significant increase in the compressive strength, bricks treated with B. pasteurii grown in OptU media resulted in 48.9 % reduction in water absorption capacity as compared to control bricks immersed in tap water. Thus it was successfully demonstrated that microbial calcification in optimized media by Bacillus pasteurii has good potential for commercial application to improve the life span of structures constructed with bricks, particularly structures of heritage importance.
Similar content being viewed by others
Explore related subjects
Discover the latest articles, news and stories from top researchers in related subjects.Avoid common mistakes on your manuscript.
Introduction
Bricks have thrived over thousands of years due to their durability, longevity and a number of factors that contribute to their inherent sustainability. Bricks masonry constitutes a significant part of the construction materials found in historic buildings. Early deterioration of civil structures occurs due to presence of voids and pores which subsequently results into cracks (Sarode and Mukherjee 2009). There are several voids and in-homogeneities in bricks at the micro-level which can affect the durability of bricks. In order to ensure that the strength and performance of fired clay bricks is maintained, the need to increase its durability must be considered. On exposure to aggressive environments, the durability of fired clay bodies is affected (Bakar et al. 2011). The most common type of defects that can develop in bricks and masonry structures include cracking, fretting and spalling. Durability of bricks is considered to be closely related to its compressive strength and resistance to water permeation. The compressive strength of bricks depends on its textural and microstructural characteristics whereas the impermeability of water in bricks depends on its porosity (Elert et al. 2003; Sarda et al. 2009). Several construction materials are deteriorated as a result of the weathering action of various physical, chemical and biological factors in the environment. Several chemically organic and inorganic conservation treatments have been applied to reduce the susceptibility of civil engineering structures to decay. However these chemical treatments are subject to frequent controversy due to their limited performance and nonreversible action on materials used in construction (Muynck et al. 2010). Several insoluble organic and inorganic compounds are produced intra- or extracellularly by microorganisms as a result of their metabolic activities. Biocalcification phenomenon, also known as microbiologically induced calcite precipitation (MICP), occurs in the environment due to the metabolic activity of microbes, especially urease-producing organisms. Urease enzyme produced by these microorganisms can influence precipitation of calcium carbonate. This enzyme catalyzes the hydrolysis of urea to CO2 and ammonia, resulting in an increase in alkalinity and carbonate concentration in the microbial environment (Chahal et al. 2011).
The actual role of the microbes in carbonate precipitation yet remains a matter of debate. Some authors believe this microbial precipitation to be an unwanted and accidental by-product of the metabolism (Knorre and Krumbein 2000), while others think that it is a specific process with ecological benefits for the precipitating organisms (Ehrlich 1996; McConnaughey and Whelan 1997). This naturally occurring phenomenon, if employed as a novel technique for remediation of damaged civil engineering structures, can result in selective microbial plugging of the cracks and thereby re-consolidating the distorted structure. Dhami et al. (2012a) and Sarda et al. (2009) have demonstrated the beneficial impact of biocalcification on the durability of bricks. Several researchers have used standard available media or cheaper alternatives to support the growth and urease activity of microbes to develop microbial concrete (Achal et al. 2009a, b, 2010). Annamalai et al. (2012) studied the microbiological remediation efficiency of B. pasteurii grown in a media optimized for highest production of calcium carbonate and reported that the enhancement in strength of cement mortar cubes subjected to longer incubation period of 28 days in this media was only marginal as compared to cubes incubated for 7 days. Muynck et al. (2010) concluded that fast precipitation of calcium carbonate could result in a lower efficiency of the biodeposition treatment. Thus for enhancement in efficiency of microbiological remediation process, high but controllable precipitation of calcium carbonate is essential. Urease enzyme is known to be directly associated with the biocalcification activity (Ariyanti et al. 2012; Bachmeier et al. 2002). Sarda et al. (2009) have reported that B. pasteurii in NB produces significant quantity of urease enzymes that lead to strengthening of bricks due to biocalcification. Sarda (thesis) reported further that B. pasteurii grown in media optimized for urease production (OptU) produced 143.81 % more urease. However, the results were not validated on bricks. This work was undertaken with the objective of comparison of biocalcification efficiency of B. pasteurii NCIM 2477 grown in OptU and standard media. Strengthening effect was estimated in terms of compressive strength and water absorption capacity of standard clay bricks. Studies were also performed to evaluate various physico-chemical changes occurring during the 28 days curing period to get precise details of this complex process.
Materials and methods
Microorganism and media
Standard Bacillus pasteurii (NCIM 2477) was used in this biocalcification studies. The standard Nutrient Broth (NB) and OptU media were used to demonstrate, quantify and compare the efficiency of Microbial Induced Calcite formation by Bacillus pasteurii in clay bricks. The composition of OptU media (22 g/l glucose, 3.4 g/l yeast extract, 23.5 g/l urea, 0.05 g/l MgSO4.7H2O, 0.03 g/l NiSO4.6H2O, 0.04 g/l CaCl2, 5.5 g/l KH2PO4 and 0.35 g/l K2HPO4) was optimized by one factor at a time, followed by Response Surface Method (RSM) for maximum urease enzyme production by B. pasteurii. (Details of methods for optimization of OptU media are provided as Supplementary material).
Microbial calcite deposition in bricks
Conventional red bricks (composed of 80 % clay, 15 % ash and 5 % rice husk) of size 220 mm × 100 mm × 70 mm were procured from a local kiln (Patil Bricks, Palghar, Maharashtra, India). NB and OptU media were prepared and autoclaved in 25 L capacity autoclavable Carboy (Tarsons). Plastic containers were purchased from local shop, thoroughly alcohol sterilized and filled with sterile NB, sterile OptU media and water respectively. Sterile NB were inoculated with Bacillus pasteurii culture suspension and incubated for 24 h under shaker conditions, 180 rpm. Unless otherwise mentioned, all incubations at flask level were performed under shaker conditions at 180 rpm. Pellets were separated by centrifugation (15 °C, at 10,000 rpm for 15 min) and inoculated in the sterile NB for growth of seed culture. After 24 h, the pellets of seed culture were extracted, washed and dispensed in saline (OD660 of 1.5). The plastic containers containing the sterile NB and sterile OptU media were inoculated with saline culture suspension, after which dried bricks were immersed in the inoculated OptU media and NB respectively. Dried bricks immersed in water (no bacteria added) for curing served as control specimens. Separate media controls were not used based on results obtained in the flask level experiments where the CaCO3 precipitated in un-inoculated media due to chemical reaction was negligible (only 15.8 and 22.8 % as compared to inoculated optimized and standard media respectively). The results reported by Achal et al. (2011) also proved that compressive strength and water absorption percentage of cement mortar cubes cured in water and in un-inoculated media were almost same. After 24 h of incubation, membrane sterilized urea-CaCl2 (2 % Urea, 0.3 % CaCl2) solution was added aseptically to all the inoculated containers. The curing process was allowed to occur and at the intervals of 7, 14, 21 and 28 days, bricks were removed and dried.
Water absorption test for bricks
Water Absorption test was done as per IS 3495. Dried bricks after the curing process in water and both the inoculated media were saturated overnight in water and weighed. The bricks were then dried in an oven at 100 °C for 24 h followed by sufficient cooling and weighed again. Following formula was used to calculate % water absorption in the treated bricks.
Wsaturation = weight of bricks after saturation for 24 h in water; Woven dried = weight of bricks after oven drying for 24 h at 100 °C
Bricks cured in water were considered as control for comparison with bricks cured in NB and OptU media inoculated with culture suspension.
Compressive strength of bricks
After 7, 14, 21 and 28 days of curing, the bacteria treated and un-treated bricks were dried. The frogs on the surface of the bricks were filled with cement mortar capping (1 cement: 3 sand) and stored under the damp jute bags for 24–48 h. The compressive strength test was done on bricks in accordance with IS 3495 and using compression testing machine.
Urease and urea analysis
The phenol–hypochlorite assay method (Natarajan 1995) was used to determine urease activity in both the Bacillus inoculated media for up to 28 days. One unit of urease is defined as the amount of enzyme hydrolyzing 1 μmol urea/min. A modified phenol hypochlorite assay method was used to estimate the quantity of un-utilized urea in both the media to get an estimate of amount of urea breakdown due to microbial urease activity. The modification involved treating supernatant obtained by centrifuging fixed aliquots of samples from each of the inoculated media containing un-hydrolyzed urea left during the curing process with standard urease enzyme (Sigma Aldrich). The quantity of un-hydrolyzed urea was extrapolated using standard graph of urea against optical density.
Microbial count and pH
The pH of the both inoculated media was monitored after 3–4 days interval up to 28 days. Aliquots of samples from each of the inoculated media were subjected to microbial analysis. Spread plate technique was used for microbial analysis. Christensen’s urea agar was used to selectively estimate the number of urease producing bacteria in both the inoculated media and to ensure the survival of sufficient urease-producers in the 28 days experimental set-up.
Cell-bound and dissolved calcium
Ion Selective Electrode (ISE Meter, Orion, Thermo Scientific) was used to estimate the cell-bound and dissolved calcium. Cell-bound calcium was extracted by centrifuging aliquots of samples from the inoculated tubs. Pellets extracted were suspended in phosphate buffer (pH 7) and further subjected to sonication using a probe-sonicator (Branson sonifier 450). Sonicated sample was centrifuged and the supernatant was used to estimate cell-bound calcium released during the sonication process due to cell lysis. Dissolved calcium was directly estimated by subjecting aliquots of samples from the inoculated tubs to centrifugation, followed by estimation of calcium ions in the supernatant as dissolved or un-precipitated calcium.
Characterization of deposits
The morphology and chemical constituents of the crystals precipitated by B. pasteurii on the surface of the bricks cured in inoculated NB and OptU media was analyzed by SEM, EDX and XRD. Completely dried samples were coated with Platinum using JEOL JFC 1600 Auto fine coater prior to examination. SEM micrographs were obtained using JEOL JSM 6380 LA Analytical Scanning Electron Microscope at voltage ranging from 15 to 20 kV. X-ray diffraction (XRD) technique was used to determine components in the bacterially precipitated crystals. XRD-spectra were obtained using monochromatic CuKα radiation (40 kV and 30 mA) and scanning from 10° to 80° 2θ. The most prominent components of the sample were identified by comparing with standard established by the International Center for Diffraction data. Mineral constituents of the precipitate were further characterized by EDX.
All the experiments were performed in triplicate. Data were analyzed by analysis of variance (ANOVA) and the means were compared by Turkey’s test using SPSS software.
Results
Growth profile and pH
Survival and growth of urease producing bacteria is very essential for biocalcification activity to take place (Zamarreño et al. 2009a). The cfu/ml of B. pasteurii was monitored for 28 days in order to ensure that sufficient numbers of B. pasteurii cells survived to allow continued biocalcification process. The growth profile of B. pasteurii was monitored at frequent intervals and Fig. 1a shows that B. pasteurii has the ability to grow well in both NB and OptU media. In order to ensure that B. pasteurii culture added on Day 1 survived for 28 days, aliquots of media used for curing bricks were plated on Christensen’s urea agar to determine the exact cell count of the B. pasteurii cells (pink colonies) and also to get an idea of the extend of contaminants (colorless colony) surviving in the media. A significantly high number of B. pasteurii cells were observed for 28 days in OptU media in comparison to the contaminants. Unlike the OptU media, the NB initially also supported the growth of the other contaminants. However since every week only 10 % of the media was replenished along with Urea and CaCl2, the B. pasteurii cells growing in NB also had a better competitive growth advantage over the other contaminants after 1 week.
The pH of the inoculated NB and OptU media varied during the 28 days period but did not exceed a pH value of 10.69 (Fig. 1b). However in the initial 2–3 weeks the pH of the OptU media was much higher than NB due to high urease activity of B. pasteurii in OptU media that results in release of higher concentration of ammonium ions from the enzymatic urea hydrolysis.
Urease
The urease activity of B. pasteurii in NB and OptU media also gradually decreased by the end of each week due to nutrient depletion but on replenishment of media constituents, a rapid increase in urease activity within 24 h was observed (Fig. 2). Urease activity is maximum during exponential phase of growth. For replenishment, 10 % media, urea and CaCl2 of same concentration was used. Similar pattern was observed during each of the 4 weeks, however each week after the media replenishment, the urease activity of B. pasteurii increased significantly within 24 h in comparison to the increase in urease activity due to media replenishment in the previous week. The urease activity of B. pasteurii in OptU media was 35.10, 63.22, 71.53 and 80.72 U/ml on 3rd, 8th, 15th and 22nd day respectively. The urease activity of B. pasteurii in NB was 10.44, 24.12, 29.24 and 37.20 U/ml on 3rd, 8th, 15th and 22nd day respectively. As the nutrient availability and the cfu/ml of B. pasteurii depletes by the end of each week, the urease activity also gradually depleted in both the media.
Urea hydrolyzed and CaCO3 precipitation
The Figs. 3a and 3b indicate the amount of urea added each week and the extent of urea depletion as a result of enzymatic urea hydrolysis by B. pasteurii in OptU media and NB. Out of the total urea added, a 99.46 % urea breakdown was observed over the 28 days incubation period due to urease activity of B. pasteurii in OptU media. The urease activity of B. pasteurii in NB resulted in 43.49 % urea breakdown over a period of 28 days period. The Fig. 4a, b indicate the amount of free calcium added and the amount of free calcium left un-precipitated in the media during the curing process. The extent of biocalcification by B. pasteurii in OptU media was extremely high in comparison to biocalcification in NB. Dhami et al. (2012b) emphasized on the probable role of bacterial surfaces in microbial induced calcite precipitation by acting as a nucleation site for calcite precipitation. The Fig. 5 indicates the extent of cell-bound calcium during the 28 days curing process, thus indicating the active role of newly formed B. pasteurii cells in the biocalcification process. Over a period of time due to continued biocalcification process, these cells get embedded in the growing carbonate crystals.
Characterization of precipitate
The morphology and chemical constituents of microbiologically precipitated crystals were analyzed with SEM, EDX and XRD. SEM analysis of microbial precipitate formed in OptU media revealed presence of both rhombohedral as well as spherical crystals along with bacterial cells (Fig. 6a). Only rhombohedral crystals along with bacterial cells were observed by SEM analysis in microbial precipitate formed in NB (Fig. 6b). Shirakawa et al. (2011) proved that the biocalcification ability of the microbes depends on the culture media used for its growth. The composition of the growth medium also influences the type of carbonate precipitated (Zamarreño et al. 2009b). Mineral constituents in the microbial precipitate were further characterized by EDX. Calcium was found to be the major mineral constituent in microbial precipitate formed in both OptU media and NB, as was confirmed by EDX. XRD revealed presence of both calcite and vaterite as the major components present in microbial precipitate formed in OptU media whereas only calcite was observed as a predominant component in the precipitate formed in NB. Conversion of vaterite to calcite occurs rapidly in the presence of water, with almost all vaterite converting to calcite within a period of 24 h (Crawford et al. 2011). Thus SEM, EDX and XRD results confirm that majority of precipitate deposited by B. pasteurii in both OptU and NB media constitutes of calcium carbonate in the form of calcite.
Water absorption test
To determine the increase in resistance towards water absorption in bricks, a water absorption test was performed. Figure 7 shows the influence of the biocalcification process on water absorption capacity of bricks. Over a period of 28 days, it was observed that the water absorption capacity of the bricks specimens cured in B. pasteurii inoculated OptU media and NB was reduced by 48.9 and 19.95 % respectively compared to the control specimens. This indicates that the pores in the bricks were blocked as a result of calcite deposition, thereby resisting penetration of water and other pollutants into the body of bricks. Dhami et al. (2012a) has also reported a measurable reduction in water absorption capacity of bricks by application of B. pasteurii. However the reduction in water absorption capacity as a result of biocalcification activity of B. pasteurii grown in OptU media was significantly more than in NB. Decrease in water absorption will lead to reduction in rate of deterioration and dampness spread. The enhanced retardation to absorption of water in bricks cured in B. pasteurii inoculated OptU media proves the efficiency of OptU media in increasing the durability and longevity of civil brick structures.
Compressive strength test
The Compressive strength test was performed to check the extent of improvement upon treatment with bacterial calcite produced by B. pasteurii in NB and OptU media. The compressive strength of bricks increased due to microbial calcite precipitation as compared to control irrespective of the media used to grow the B. pasteurii cells (Fig. 8). The highest compressive strength (7.54 N/mm2) was obtained with bricks that were cured in B. pasteurii inoculated OptU media for 28 days. Bricks cured in B. pasteurii inoculated OptU media showed around 83.9 % improvement in compressive strength after 28 days with respect to control (4.1 N/mm2); whereas in case of bricks cured in B. pasteurii inoculated NB, the improvement in strength was only 24.9 % as compared to control. The difference in enhancement of compressive strength of bricks cured in B. pasteurii inoculated OptU media and NB was highly significant at 7th, 14th, 21st as well as 28th day. Deposition of CaCO3 due to continued biocalcification activity of bacterial cells on the surface and within the pores of the bricks results in enhancement of the compressive strength of the bricks (Dhami et al. 2012a). The improvement of compressive strength of cement mortars due to biocalcification activity of Shewanella species has been demonstrated by Ghosh et al. (2005).
Discussion
At the end of each week, the cfu/ml of B. pasteurii gradually decreased due to nutrient depletion. However B. pasteurii is a sporulating bacteria, hence its spores still remain in the media. On replenishment of media components each week, a drastic increase in cfu/ml of B. pasteurii cells was observed due to conversion of spores into vegetative cells as a result of nutrient availability. The ammonium ions released by urea hydrolysis increased the pH of the media. However carbon dioxide released from microbial respiration and the carbonate or bicarbonate ions produced in the media due to enzymatic urea hydrolysis, on the contrary, acted as buffer to the pH rise, thereby resisting a further rise in the pH after a particular level (Fischer et al. 1999; Ng et al. 2012). Despite of the rise in the pH, upon replenishment of media components due to the microbial urease activity, a decline in the pH was also observed in both NB and OptU media by the end of each week. This may be due to utilization of the generated ammonium ions by the microorganisms for other purposes. The influence of ammonium and urea on the components of the proton electrochemical potential (delta p) and de novo synthesis of Adenosine-5′-triphosphate (ATP) has been demonstrated previously in Bacillus pasteurii ATCC 11859 (Arioli et al. 2010; Jahns 1996). Koyama (1993) has demonstrated stimulation of amino acid transport due to the direct activation of a sodium translocating ATP hydrolyzing enzyme (ATPase) by ammonium in Amphibacillus xylanus. Ammonium-dependent transport of glucose has also been reported in a facultatively anaerobic alkalophile (Koyama 1989).
In each week, the increase in urease activity within 24 h after the media replenishment was much higher than the increase in urease activity after media replenishment in the previous weeks. This would probably have been due to the increase in cfu/ml each week within 24 h after every replenishment, as spores present in media before replenishment revived into vegetative cells after replenishment. These cells further multiplied during their growth phase ultimately resulting in more number of spores at the end of that week due to nutrient depletion. Thus as the cfu/ml increased each week, the corresponding urease activity increased accordingly. Other reason for this would also be the adaption of B. pasteurii cells to high concentration of urea over a period of 28 days. Media being especially designed for maximum urease production by B. pasteurii, the urease activity observed in OptU media was much greater than urease activity of B. pasteurii grown in NB. Maximum urease production was demonstrated in Klebsiella species by optimizing various physico-chemical parameters using one factor at a time methodology (Balan et al. 2012).
Microbiologically induced calcite precipitation is a far more complicated process than the chemical induced precipitation. The ratio of urea depletion to calcite precipitation in this experimental system was not as similar to the ideal 1:1 ratio observed in the chemical induced calcite precipitation. Similar observations were reported by Ferris (2003) and Phoenix and Ferris (2002) wherein dissolved Ca2+ depletion over time did not appear to correlate directly with the rates of urea hydrolysis. Thus the CO2 released by urea hydrolysis may be used for other metabolic activities. Mulrooney and Hausinger (2003) have demonstrated the requirement of CO2 in activation of urease enzyme. CO2 is a pyrimidine and purine precursor and is incorporated into their structures (Makoff and Radford 1978; Moat et al. 2002). Knorre and Krumbein (2000) raised the probability of calcite precipitation to be an unwanted and accidental by-product of the microbial metabolism.
In this study, compressive strength and resistance to water permeation were used as important parameters to determine the impact of microbiologically induced calcite precipitation on durability of bricks. Unlike other researchers (Achal et al. 2009a; Vempada et al. 2011), the microbial cells were inoculated into the media used for curing the specimens and not directly added within the specimens. The main purpose of this modification was to increase availability of maximum nutrients added in the media to the B. pasteurii cells. Cells incorporated in bricks material are entrapped and devoid of nutrients during the casting process which results in spore formation. For the spores to get converted into vegetative cells and to further become metabolically active, availability of sufficient nutrients is very essential. Achal et al. (2009a) have shown the limitation of directly incorporating microbes within the cement mortars on growth of the microbes. Jonkers and Schlangen (2007) and Jonkers et al. (2010) have reported no difference in compressive strength and surface cracks of bacteria treated and control specimens after 28 days, due to decrease in viability of spores upon incorporation in the cement matrix.
Incorporating microbes within the body of material will affect the extent of nutrient and oxygen availability to the microbes which in turn affects their biocalcification ability. During the initial curing period, the bacterial cells inoculated directly in the nutrient media readily utilized the available nutrients and became metabolically active. The voids and in-homogeneities in bricks at micro level allowed the gradual penetration of already metabolically active microbes along with the nutrients into the pores thereby facilitating the microbial calcite deposition into these pores. These metabolically active B. pasteurii cells precipitated calcite within the pores as well as on the surface of the bricks. There was 47.27 % increase in compressive strength of bricks cured for 28 days in OptU media as compared to specimens cured in NB (5.12 N/mm2). Incorporation of B. megaterium in fly ash bricks has been reported to increase the compressive strength of bricks by only 21.8 % with respect to control specimens after 28 days using NB supplemented with urea and CaCl2 (Dhami et al. 2012a). Bricks cured in B. pasteurii inoculated OptU media also showed a drastic reduction (36.17 %) in water absorption capacity as compared to NB. Sarda et al. (2009) had also reported only 14.1 % reduction in water absorption capacity of bricks cured in B. pasteurii inoculated NB as compared to control. In addition to sealing of the pores inside the bricks by the enhanced microbial calcite precipitation by B. pasteurii in OptU media, the higher number of endospores formed on cell death with organic fiber properties may also have served as an organic sealant to enhance the compressive strength of bricks (Achal et al. 2009a, b). The use of OptU media as a curing media for the biocalcification process resulted in 13.3 % cost savings as compared to NB. Although cheaper alternatives (Achal et al. 2009a, 2010) have been used as a curing media to allow the biocalcification process to take place, however the enhancement in durability of civil engineering materials using B. pasteurii inoculated OptU media is significantly high as compared to control specimens. In contrast to 83.9 % improvement in compressive strength of bricks cured in B. pasteurii inoculated OptU media after 28 days, mixing of S. pasteurii in mortar cubes with cheaper alternatives like lactose mother liquor-urea and corn steep liquor-urea medium resulted only in 17 and 35 % improvement in compressive strength at 28 days as compared to control (Achal et al. 2009a, 2010).
Considering the fact that practical application of microbial calcite precipitation is still in its early stages of implementation, it is recommended that the technique should initially be applied selectively as it will require skilled manpower to avoid contamination. Many other researchers have shown that the micro voids and cracks in bricks, cement mortar and concrete can be successfully remediated with this technique. This technique can be used for the repair and strengthening of monumental, historically significant structures and structures of strategic importance. Practical applications of biocalcification process for remediation of several historic monuments have been successfully proven in France (Dhami et al. 2012b). Based on the findings of this paper, it is suggested that to enhance the field efficiency of the biocalcification treatment on more industrial scale, damaged part of the building should be initially subjected to application of 24 h old Bacillus inoculated OptU media along with urea- CaCl2 solution. After each week up to 28 days period, only 10 % of the media constituents dispensed in sufficient quantity of water along with urea-CaCl2 solution should be applied to the material being treated to obtain sufficient plugging of pores and filling of cracks in the damaged portions. In case of biocalcification treatment using NB, periodic applications of media nutrients over several days may be required for improving the efficiency of this treatment.
Gradually over a period of time, biocalcification can be used to repair of cracks in nuclear structures or repairs of the part of the structure at inaccessible location, as it is one of the most difficult operations. The position of structural distress can be located using sensors. During the construction of nuclear structures, conduits should be laid in the body of the structure. They will be used to give the nutrient and urea-CaCl2 at the position of distresses. To avoid corrosion of reinforcement steel in the structures, calcium acetate or dairy waste can be used as source of calcium (Achal et al. 2009a, 2011).
Conclusion
The present study suggests that OptU media can serve as a better curing media for allowing MICP by B. pasteurii in comparison to standard growth media. A tremendous improvement in compressive strength and impermeability to water was seen in bricks subjected to biocalcification activity of B. pasteurii grown in OptU media as compared to control specimens. This can favorably reduce the frequency of required maintenance for civil structures constructed in bricks and the environment concern associated with it. Thus microbial induced calcite precipitation by B. pasteurii grown in OptU media will be of immense help in the preservation of monumental structures constructed with bricks.
References
Achal V, Mukherjee A, Basu PC, Reddy MS (2009a) Lactose mother liquor as an alternative nutrient source for microbial concrete production by Sporosarcina pasteurii. J Ind Microbiol Biotechnol 36:433–438. doi:10.1007/s10295-008-0514-7
Achal V, Mukherjee A, Basu PC, Reddy MS (2009b) Strain improvement of Sporosarcina pasteurii for enhanced urease and calcite production. J Ind Microbiol Biotechnol 36:981–988. doi:10.1007/s10295-009-0578-z
Achal V, Mukherjee A, Basu PC, Reddy MS (2010) Biocalcification by Sporosarcina pasteurii using corn steep liquor as nutrient source. Ind Biotechnol 6(3):170–174. doi:10.1089/ind.2010.6.170
Achal V, Mukherjee A, Reddy MS (2011) Microbial concrete: way to enhance the durability of building structures. J Mater Civ Eng 23(6):730–734. doi:10.1061/(ASCE)MT.1943-5533.0000159
Annamalai SK, Arunachalam KD, Sathyanarayanan KS (2012) Production and characterization of biocaulk by bacillus pasteurii & its remediation properties with carbon nano tubes on concrete fractures and fissures. Mater Res Bull 47(11):3362–3368. doi:10.1016/j.materresbull.2012.07.024
Arioli S, Ragg E, Scaglioni L, Fessas D, Signorelli M et al (2010) Alkalizing reactions streamline cellular metabolism in acidogenic microorganisms. PLoS ONE 5(11):e15520. doi:10.1371/journal.pone.0015520
Ariyanti D, Handayani NA, Hadiyanto H (2012) Feasibility of using microalgae for biocement production through biocementation. J Bioprocess Biotechniq 2:111. doi:10.4172/2155-9821.1000111
Bachmeier KL, Williams AE, Warmington JR, Bang SS (2002) Urease activity in microbiologically-induced calcite precipitation. J Biotech 93:171–181
Bakar BHA, Ibrahim MHA, Johari MAJ (2011) A review: durability of fired clay brick masonry wall due to salt attack. Int J Integr Eng 1(2):111–127
Balan S, Fazila F, Jayalakshmi S (2012) Characterization of urease enzyme from marine bacterium Klebsiella species. Afr J Microbiol Res 6(30):5914–5923. doi:10.5897/AJMR12.218
Chahal N, Rajor A, Siddique R (2011) Calcium carbonate precipitation by different bacterial strains. Afr J Biotechnol 10(42):8359–8372. doi:10.5897/AJB11.345
Crawford RL, Burbank MB, Weaver TJ, Williams BC (2011) In situ precipitation of calcium carbonate (CaCO3) by indigenous microorganisms to improve mechanical properties of a geomaterial. Patent application No: 20110027850
Dhami N, Reddy S, Mukherjee A (2012a) Improvement in strength properties of ash bricks by bacterial calcite. Ecol Eng 39:31–35. doi:10.1016/j.ecoleng.2011.11.01110
Dhami N, Reddy S, Mukherjee A (2012b) Advanced topics in biomineralization. In: Dr. Jong Seto (ed) Biofilm and microbial applications in biomineralized concrete, pp 137–164. doi: 10.5772/31124
Ehrlich HL (1996) How microbes influence mineral growth and dissolution. Chem Geol 132:5–9. doi:10.1016/S0009-2541(96)00035-6
Elert K, Cultrone G, Rodriguez CN, Pardo ES (2003) Durability of bricks used in the conservation of historic buildings—influence of composition and microstructure. J Cult Herit 4:91–99. doi:10.1016/S1296-2074(03)00020-7
Ferris FG (2003) Calcite precipitation and trace metal partitioning in groundwater and the vadose zone: remediation of strontium-90 and other divalent metals and radionuclides in Arid Western Environments Project Number: 70206 http://www.osti.gov/bridge/purl.cover.jsp?purl=/809819-fzR8yA/native/809819.pdf
Fischer SS, Galinat JK, Bang SS (1999) Microbiological precipitation of CaCO3. Soil Biol Biochem 31:1563–1571. doi:10.1016/S0038-0717(99)00082-6
Ghosh P, Mandal S, Chattopadhyay BD, Pal S (2005) Use of microorganism to improve the strength of cement mortar. Cem Concr Res 35(10):1980–1983. doi:10.1016/j.cemconres.2005.03.005
Jahns T (1996) Ammonium/urea-dependent generation of a proton electrochemical potential and synthesis of ATP in Bacillus pasteurii. J Bacteriol 178(2):403–409. doi:10.1021/bi970326t
Jonkers H, Schlangen E (2007) Crack repair by concrete-immobilized bacteria.Proceedings of the First International Conference on Self Healing Materials 18-20 April 2007, Noordwijk aan Zee, The Netherlands
Jonkers H, Thijssen A, Muyzer G, Copuroglu O, Schlangen E (2010) Application of bacteria as self-healing agent for the development of sustainable concrete. Ecol Eng 36:230–235. doi:10.1016/j.ecoleng.2008.12.036
Knorre H, Krumbein W (2000) Bacterial calcification. In: Riding RE, Awramik SM (eds) Microbial Sediments. Springer, Berlin, pp 25–31
Koyama N (1989) Ammonium-dependent transports of amino acids and glucose in a facultatively anaerobic alkalophile. FEBS Lett 253:187–189. doi:10.1016/0014-5793(89)80956-1
Koyama N (1993) Stimulatory effect of NH4 + on the transport of leucine and glucose in an anaerobic alkaliphile. Eur J Biochem 217:435–439. doi:10.1111/j.1432-1033.1993.tb18263.x
Makoff AJ, Radford A (1978) Genetics and biochemistry of carbamoyl phosphate biosynthesis and its utilization in the pyrimidine biosynthetic pathway. Microbiol Rev. 42(2):307 http://www.ncbi.nlm.nih.gov/pmc/articles/PMC281432/
McConnaughey TA, Whelan JF (1997) Calcification generates protons for nutrient and bicarbonate uptake. Earth Sci Rev 42:95–117. doi:1016/S0012-8252(96)00036-0
Moat AG, Foster JW, Spector MP (2002) Microbial physiology. Purines and pyrimidines, 4th edn. Wiley-Liss, New York, pp 545–560
Mulrooney SB, Hausinger RP (2003) Nickel uptake and utilization by microorganisms. FEMS Microbiol Rev 27:239–261. doi:10.1016/S0168-6445(03)00042-1
Muynck W, Belie N, Verstraete W (2010) Microbial carbonate precipitation in construction materials: a review. Ecol Eng 36:118–136. doi:10.1016/j.ecoleng.2009.02.006
Natarajan KR (1995) Kinetic study of the enzyme urease from Dolichos biflorus. J Chem Educ 72:556–557. doi:10.1021/ed072p556
Ng WS, Lee ML, Hii SL (2012) An overview of the factors affecting microbial-induced calcite precipitation and its potential application in soil improvement. WASET 62:723–729
Phoenix VR, Ferris FG (2002) Kinetics of calcite precipitation induced by ureolytic bacteria at 10–20 °C in artificial groundwater. American Geophysical Union, Fall Meeting 2002, abstract #B11B-0727. Bibliographic Code:2002AGUFM.B11B0727P
Sarda D, Choonia H, Sarode DD, Lele SS (2009) Biocalcification by Bacillus pasteurii urease: a novel application. J Ind Microbiol Biotechnol 36:1111–1115. doi:10.1007/s10295-009-0581-4
Sarode DD, Mukherjee A (2009) Concrete solutions. Microbial precipitation for repairs of concrete structures, CRC Press, pp 191–198. doi: 10.1201/9780203864005.ch33
Shirakawa MA, Cincotto MA, Atencio D, Gaylarde C, Vanderley J (2011) Effect of culture medium on biocalcification by Pseudomonas putida, Lysinibacillus sphaericus and Bacillus subtilis. Braz J Microbiol 42(2):499–507. doi:10.1590/S1517-83822011000200014
Vempada SR, Reddy S, Rao S, Sasikala C (2011) Strength enhancement of cement mortar using microorganisms: an experimental study. J Earth Sci Eng 04(06):933–936
Zamarreño D, May E, Inkpen R (2009a) Influence of environmental temperature on biocalcification by non-sporing freshwater bacteria. Geomicrobiol J 26(4):298–309. doi:10.1080/01490450902895962
Zamarreño DV, Inkpen R, May E (2009b) Carbonate crystals precipitated by freshwater bacteria and their use as a limestone consolidant. Appl Environ Microbiol 75(18):5981–5990. doi:10.1128/AEM.02079-08
Acknowledgments
The financial assistance to this study received from Rajiv Gandhi Commission for Science and Technology (RGC), Government of Maharashtra, India is gratefully acknowledged. The authors are thankful to Structural Department, VJTI, Mumbai, India for the experimental facilities. The authors have declared no conflict of interest.
Author information
Authors and Affiliations
Corresponding author
Electronic supplementary material
Below is the link to the electronic supplementary material.
Rights and permissions
About this article
Cite this article
Raut, S.H., Sarode, D.D. & Lele, S.S. Biocalcification using B. pasteurii for strengthening brick masonry civil engineering structures. World J Microbiol Biotechnol 30, 191–200 (2014). https://doi.org/10.1007/s11274-013-1439-5
Received:
Accepted:
Published:
Issue Date:
DOI: https://doi.org/10.1007/s11274-013-1439-5